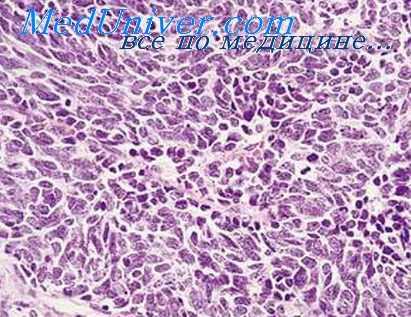
осложнения лучевой болезни

Инфекционные осложнения лучевой болезни. Инфекция в облученном организме
Добавил пользователь Алексей Ф. Обновлено: 28.10.2025
Введение
70 лет назад в нашей стране началось создание специализированных научно - клинических учреждений для изучения методов диагностики и лечения ранее неизвестного класса болезней, этиология которых обусловлена воздействием ионизирующего излучения на организм человека. Спустя 25 лет, в середине 1970 - х гг. прошлого века в нашей стране произошло наибольшее количество радиационных аварий, сопровождавшихся облучением человека с последующим развитием острой лучевой болезни (ОЛБ), что послужило толчком к изучению детерминированной лучевой патологии человека [1].
Известно, что различные дозы облучения могут приводить к повреждению разных биологических структур клетки, но наиболее четко очерченные дозовые зависимости выявлены для биологических эффектов, возникающих вследствие повреждения ионизирующим излучением ДНК. Стало понятно, что ДНК является структурой, для которой характерна наибольшая вероятность повреждения проникающей радиацией по сравнению с другими структурными элементами клетки. Вероятно, одной из причин тому является гигантский размер молекулы ДНК по сравнению с молекулами других органических веществ, присутствующих в живой клетке. Очевидно, что чем крупнее объект, тем вероятнее столкновение с ним квантов проникающей радиации. Поэтому теория «мишеней» и принцип «попадания», предложенные Н.В. Тимофеевым-Ресовским, позволяет объяснить механизмы запуска большинства клинических эффектов ионизирующей радиации [2].
А.К. Гуськова и Г.Д. Байсоголов, создавая первые клинические описания случаев лучевой болезни, имевших место у персонала первенца атомной промышленности ПО «Маяк», обратили внимание на то, что лучевая болезнь человека может клинически протекать остро или хронически в зависимости от пространственно-временных особенностей накопления дозы облучения [1, 3]. также авторы первой клинической монографии, посвященной лучевой болезни, допускали возможность существования у человека промежуточного варианта лучевой болезни, отличающегося подострым течением, однако ввиду относительной редкости возникновения условий, в которых она может возникнуть, не стали вносить ее в предложенную ими первую классификацию лучевой болезни.
Материал и методы
Исследование было выполнено путем изучения опыта диагностики и лечения лучевой болезни, накопленного в результате радиационных аварий, произошедших в СССР и России за период более 60 лет, с общим числом лиц, заболевших лучевой болезнью различной клинической формы, порядка 3 тыс. человек. Описание указанных радиационных аварий, дозы облучения персонала и количество заболевших лучевой болезнью подробно изложено в ряде обобщающих публикаций [1, 4–9].
Результаты и обсуждение
Клинические и экспериментальные исследования последних лет в области патогенеза ОЛБ позволили существенно расширить наше понимание механизмов формирования отдельных синдромов и симптомов болезни. Клинические наблюдения за формированием ОЛБ в периоде первичной реакции и попытки купирования ее симптомов в эксперименте с использованием противорвотных препаратов известного механизма действия позволили более четко представить развитие ранних неспецифических реакций организма на острое облучение и причины их отсутствия в случаях фракционированного (пролонгированного) и хронического лучевого воздействия. Не нашла своего подтверждения гипотеза непосредственного возбуждения ионизирующим излучением рвотного центра, расположенного в продолговатом мозге человека [10]. Безусловно, рвотный центр возбуждается при возникновении ранней рвоты у больных ОЛБ, но его активация возникает за счет нервных импульсов, поступающих от внутренних органов, в структуре которых имеется достаточно большое количество энтерохромаффинных клеток.
В настоящее время можно предполагать, что развитие ранней рвоты при ОЛБ начинается с поглощения энергии квантов радиации молекулами воды, расположенными в гранулах энтерохромаффинных клеток с последующим высвобождением содержащейся в ней биологически активной субстанции, являющейся тригерным медиатором для нервных окончаний, расположенных во внутренних органах. Можно предположить, что подобный механизм запуска имеет ряд ранних неспецифических физиологически взаимосвязанных симптомов ОЛБ (тошнота, рвота, диарея, гипертермия, тахикардия, кожная эритема, артериальная гипотензия, ранний нейтрофильный лейкоцитоз, гиперферментемия и др.), возникающих в периоде первичной реакции и самостоятельно исчезающих после его завершения.
Возникновение более специфических симптомов ОЛБ (лимфоцитопения, нейтропения, тромбоцитопения, лучевой энтерит, лучевой дерматит, поражение придатков кожи и др.) имеют другой патогенетический механизм, в основе которого лежит радиационная гибель определенного количества клеток в организме [11]. Сколько клеток должно погибнуть в организме человека для развития тех или специфических симптомов, остается неизвестным, однако установлено, что чем больше погибших от облучения клеток, тем тяжелее клиническое течение ОЛБ и тем более вероятен летальный исход заболевания.
В настоящее временя можно констатировать, что биохимические и нейро-физиологические сдвиги, изменения гуморальной и вегетативной регуляции сердечно-сосудистой деятельности, функциональные изменения деятельности эндокринных желез и некоторые другие неспецифические, т.е. встречающиеся при широком круге острых заболеваний различной этиологии, симптомы в периоде формирования ОЛБ не имеют четкой дозовой зависимости, поскольку являются неспецифичными проявлениями, отражающими реакции тканей конкретного организма на острое радиационное повреждение, которое определяется не только дозой облучения, но и в существенной степени индивидуальной чувствительностью. Исходя из этого, поиск новых биомаркеров, связанных с дозой облучения организма, целесообразно вести в области молекулярно-генетических методов исследования повреждений ДНК, а также искать методики, позволяющие оценить количество погибших клеток в облученном организме.
В середине 70‑х годов прошлого века в практику лечения больных гематологическими заболеваниями была внедрена заместительная терапия компонентами клеток крови донора, что стало возможным благодаря появлению сепараторов клеток крови. Достаточное количество донорских тромбоцитов, полученных от донора на сепараторе клеток крови, давало возможность надежно контролировать постлучевую геморрагию, вызванную тромбоцитопенией в периоде разгара ОЛБ. Благодаря этому, в это время количество летальных исходов, обусловленных кровотечениями, значительно сократилось по сравнению с 1960‑ми годами.
Однако попытка использовать донорскую лейкоцитарную массу, полученную на сепараторе клеток крови, оказалась малоуспешной для профилактики и лечения инфекционных осложнений ОЛБ. До настоящего времени септические осложнения ОЛБ остаются главной причиной смерти больных в периоде разгара ОЛБ, несмотря на использование самых современных антибиотиков. Предметом текущих научных исследований являются средства и методы профилактики и лечения септицемии, инфекционных поражений ЛОР-органов и дыхательной системы. На базе современных представлений о патогенезе ОЛБ получили развитие основные направления ее лечения:
- ранняя симптоматическая терапия в периоде первичной реакции ОЛБ, направленная на купирование тяжелых проявлений первичной реакции ОЛБ (антиэметики, противодиарейные средства, альфа-адреномиметики и др.);
- ранняя патогенетическая терапия (цитокины, аллогенная трансплантация костного мозга), направленная на миелостимуляцию с целью перевода течения костномозгового синдрома ОЛБ в менее тяжелую степень;
- профилактика и лечение инфекционных осложнений в периоде агранулоцитоза;
- заместительная терапия компонентами крови в периоде разгара ОЛБ.
В 1986 г. в нашей клинике впервые в мировой практике началась эра клинического применения цитокиновых препаратов. Впервые цитокиновый препарат (GM‑CSF) был введен в организм больных ОЛБ тяжелой и крайне тяжелой степени, пострадавших в результате аварии на Чернобыльской АЭС.
Объективная оценка эффективности новой группы препаратов для патогенетического лечения стала возможной благодаря ранее разработанному А.Е. Барановым методу построения стандартных дозовых кривых гранулоцитов [11, 12]. К настоящему времени ряд рекомбинантных цитокиновых препаратов, созданных с применением технологий генной инженерии, пригодных для патогенетической терапии ОЛБ (G‑CSF, IL‑1B, тромбопоэтин, эритропоэтин и др.), существенно расширился [13]. Повышение эффективности цитокиновой терапии просматривается в комбинированном, последовательном применении этих средств, начиная с первых минут болезни и в течение всего периода ее формирования [14].
В последние годы случаи подострого течения лучевой болезни стали предметом целенаправленного исследования, поскольку данный клинический вариант отличается от классических (острая и хроническая лучевая болезнь) не только высоким процентом случаев необратимой миелодепрессии, но и крайне высоким риском смерти от гемобластозов в отдаленном периоде болезни. Целенаправленные исследования позволили выделить относительно небольшую, но четко очерченную группу больных лучевой болезнью, клиническое течение которой отличается от типичного течения как острой, так и хронической лучевой болезни, сочетая в себе отдельные симптомы как той, так и другой [15].
Заключение
Таким образом, основываясь на принципах диагностики и лечения ОЛБ, сформулированных в основном в середине 70-х годов прошлого века, удалось к настоящему времени добиться существенного роста эффективности лечения ОЛБ, существенно сократить количество летальных исходов, улучшить качество и продолжительность жизни больных с последствиями ОЛБ. Современные клинико-лабораторные технологии биологических методов определения доз облучения, диагностики, профилактики и лечения лучевой болезни существенно повышают шансы больного пережить ОЛБ. Перспективы совершенствования диагностики ОЛБ связаны с развитием методов экспресс-диагностики лучевого поражения и ранней биологической индикации дозы. Повышение эффективности лечения костномозговой формы ОЛБ связано с созданием новых фармакологических препаратов цитокинового ряда и разработкой наиболее эффективных вариантов их применения в ранней комбинированной терапии. Лечение кишечной формы ОЛБ может стать перспективным в случае появления медицинской технологи трансплантации кишечника. Перспективы эффективного лечения токсемической и церебральной форм ОЛБ в обозримом горизонте не просматриваются.
Исходя из современных теоретических представлений о нозологических единицах, полезно было бы обсудить вопрос о том, является ли лучевое повреждение организма лучевой болезнью или лучевым синдромом, а также какое общее число нозологий может быть обусловлено воздействием ионизирующего излучения.
Инфекционные осложнения лучевой болезни. Инфекция в облученном организме
Рентгеновский пульмонит. Воспаление облученного легкого
Возникающий в облученной легочной ткани комплекс изменений в свое время получил название «рентгеновский пульмонит»,, или «рентгеновская пневмония», или «лучевая пневмония». Однако в настоящее время эти определения представляются неудачными, поскольку твердо установлено, что воспаление не вызывается непосредственно действием ионизирующей радиации.
Пневмония возникает только через определенное время после облучения на фоне предшествующих изменений, составляющих собственно лучевые изменения легочной ткани. Первые значительные морфологические наблюдения в этом направлении были сделаны на людях, пострадавших в результате атомного нападения на японские города в 1945 г. [Liebow A. et al., 1949].
По данным Tullis J. с соавт. (1955), у 80% свиней, облученных при экспериментальном взрыве атомной бомбы и у-лучами в лабораторных условиях, развилась пневмония.
По данным Н. И. Мудрецова (1957), частота легочных инфекционных осложнений у собак, погибших-от острой лучевой болезни, составляет 44,9%, а ,по материалам А. Е. Иванова (1961), пневмония встречается у 5,8—11,1% облученных животных. Тем не менее' все исследователи сходятся на том, что пневмония является одним из наиболее частых инфекционных осложнений лучевой болезни, играющем важную, а иногда и решающую роль в течение и исходе заболевания.

Пневмония при острой лучевой болезни отличается большим своеобразием, нередко затрудняющим ее морфологическую диагностику. Как правило, это серозное или фибринозно-геморрагическое воспаление с экссудатом чрезвычайно бедным клеточными элементами. У японцев, умерших на 3—6-й неделе после облучения от взрыва атомной бомбы, в экссудате почти полностью отсутствовали полиморфно-ядерные лейкоциты, имелись только единичные мононуклеарные клетки, гемолизированные эритроциты, фибрин и обилие разнообразных микроорганизмов.
Эти изменения были названы «нейтропенической пневмонией». Однако в настоящее время, по-видимому, не приходится доказывать, что лейкопения, обусловленная действием ионизирующего излучения, сама по себе не является основной причиной большого своеобразия пневмоний и других воспалительных процессов в условиях острой лучевой болезни. Алейкоцитарный характер экссудата есть только одно из проявлений своеобразия тканевой воспалительной реакции, отражающей общие и местные нарушения реактивности облученного организма.
Воспалительные изменения в легких обычно обнаруживаются на высоте лучевой болезни, когда наступают наиболее глубокие сдвиги в общем иммунитете и создаются особенно грубые местные условия, облегчающие возникновение инфекционного процесса.
Информация на сайте подлежит консультации лечащим врачом и не заменяет очной консультации с ним.
См. подробнее в пользовательском соглашении.
На современном этапе развития радиобиологии проблема местного лучевого воздействия отнюдь не утратила своего значения. Напротив, в связи с применением для практических целей, кроме рентгеновских лучей и у-лучей, многочисленных естественных и искусственных источников а- и бета-излучений различной мощности, нейтронов, протонов и т. д., возросла необходимость дальнейшего изучения местных биологических эффектов, особенно в сравнительном аспекте. Однако не меньшее, если не большее, значение приобрело изучение реакции целостного организма на ту или иную форму общего облучения.
Известно, что при лучевой болезни довольно часто развиваются инфекционные осложнения, среди которых на первый план выступают такие, как некротический тонзиллит, энтерит, пневмония, инфицирование ран, термические и световые ожоги [Краевский Н. А., 1957; Иванов А. Е., 1961; Мудрецов Н. М., 1957; Tullis J., Warren Sh., 1947; Lielow A. et al., 1949; de Coursey E., 1951; Hempelmann L. et al., 1952; Oughterson E., Warren Sh., 1960].
Агенты, вызывающие воспалительные осложнения при лучевой болезни, могут быть разделены на неинфекционные и инфекционные. Неинфекционные причины нередко присоединяются в момент лучевого поражения в виде термических и химических ожогов или возникают в процессе заболевания. При определенных условиях и само ионизирующее излучение, вызывая лучевую болезнь, одновременно может быть причиной местной воспалительной реакции без участия (по крайней мере на первых этапах) инфекционного агента.
Это возможно при воздействии ионизирующего излучения в очень больших дозах, способных вызвать, кроме общего заболевания, тяжелые деструктивные изменения ножи, подлежащих мягких тканей и внутренних органов. При этом воспалительная реакция в той или иной форме вокруг омертвевших тканей начинается раньше, чем наступает инфицирование некротических масс.
Инфекционные агенты, вызывающие воспалительную реакцию в облученном организме, как правило, являются представителями аутофлоры. Само собой разумеется, что в эксперименте и в практике возможно и дополнительное экзогенное заражение.
Особенности инфекционного воспаления в облученном организме человека были подробно описаны американскими и японскими авторами, наблюдавшими (пострадавших от взрывов атомных бомб в Хиросиме и Нагасаки. Необходимо, однако, напомнить, что у переживших взрыв в большинстве случаев поражения не были «чисто» лучевыми.
У людей, подвергшихся облучению, отмечались инфекционные воспалительные изменения в полости рта, в легких и кишечнике, Эти осложнения обычно наблюдались через 2 нед после облучения в больших дозах (более 700—800 Р) и являлись очень частой причиной летальных исходов, наступающих в основном в течение 2—6 нед болезни.
Радиационные поражения легких
Радиационные поражения легких возникают при рентгенора- диотерапии по поводу рака легкого, пищевода, молочной железы и других злокачественных новообразований груди. Опасность их возникновения обусловлена относительно невысокой толерантностью легких к воздействию ионизирующих излучений, лежащей в пределах суммарной дозы облучения порядка 3000-4000 рад, которая нередко превышается в период радиационной терапии. Внедрение в практику источников высоких энергий позволяет щадить окружающие ткани, однако частота повреждений легочной паренхимы, особенно в области локализации опухоли, остается высокой [Павлов Л. С. и др., 1979]. Степень риска зависит от величины применяемой дозы и объема облучаемой легочной ткани. Имеют значение также наличие соответствующих изменений легких (например, туберкулеза), пожилой возраст, факторы индивидуальной чувствительности пациента.
Патогенез (что происходит?) во время радиоционных поражений легких:
Патогенез развивающегося радиационного пневмонита определяется: а) поражением бронхов, вызывающих развитие ателектазов с последующей соединительнотканной организацией;
б) серозна-фибринозным альвеолитом с десквамацией эпителия;
в) поражением сосудов, особенно мелких, с пролиферацией эндотелия и частичной закупоркой их просвета; г) повышенной проницаемостью капилляров с выхождением белков плазмы; д) присоединением инфекции, могущей вызвать обострение процесса и увеличение участка повреждения, которое из очагового в этом случае подчас становится диффузным.
Наиболее рано вследствие радиационного воздействия в легких повреждаются лимфоциты и лимфоидная ткань, обладающие высокой митотической активностью. Достаточно чувствительны к ионизирующим излучениям также альвео- циты I типа, которые, как известно, образуют эпителиальную выстилку альвеол и являются ответственными за газообмен. Под влиянием радиации они подвергаются некрозу и замещаются в последующем пролиферирующими альвеоцитами II типа и гранулированными альвеоцитами [Phillips Т., Wyati J. — К кн.: Fishman А., 1980].
Симптомы радиоционных поражений легких:
Различают 2 стадии: острую, или воспалительно инфильтративную, и хроническую, или фиброзную. Острая воспалительная стадия лучевых реакций легочной тканй проявляется обычно кашлем, одышкой, субфебрильной температурой. При рентгенологическом исследовании могут наблюдаться повреждения альвеолярных структур (мелкоочаговая дольковая пневмония), периброихиальные и иериваскулярпые изменения (усиление прикорневого и легочного рисунка). Эти изменения чаще появляются к концу лечения или после него и сохраняются в течение 1-4 мес.
Наблюдаются и более тяжелые повреждения легких с возникновением высокой лихорадки (до40°С), цианоза, резких нарушений дыхания и острой дыхательной недостаточности, на фоне которой могут наступать смертельные исходы. Тяжелое течение радиационного пневмонита, отмеченное у 33 % облученных пациентов (6 % из них погибли), описано, например, при проведении повторных курсов лучевой терапии, а также при тотальном облучении всего легкого вследствие метастазирования опухолей [Phillips Т., Wyatt J. - В кн.: Fishman А., 1980].
При менее тяжелых поражениях изменения острой фазы лучевой реакции могут подвергаться обратному развитию или переходить в хроническую, фиброзную, стадию. Ведущим симптомом последней является кашель, иногда боли в груди вследствие ограниченного плеврита. При физикальном исследовании резких изменений дыхания обычно не наблюдается. Иногда над областью поражения выслушиваются нестойкие разнокалиберные влажные хрипы. Рентгенологически определяется ограниченное (на стороне поражения) усиление легочного рисунка. Однако нередко процесс продолжает прогрессировать. При рентгенологическом исследовании в этих случаях обнаруживаются местная или общая деформация легочного рисунка, фиброзные изменения легких, которые подчас сопровождаются бронхоэктазами и деформацией бронхов. Может выявляться цирроз или карнпфикацня отдельных сегментов или долей. Средостение смещается в сторону пораженного легкого, нередко наблюдается деформация диафрагмы. Могут регистрироваться плевродиафрагмальные сращения, линейные тени по ходу междолевых щелей, иногда выпот в полость плевры, отражающие плевральную реакцию па облучение.
При исследовании функции внешнего дыхания обнаруживаются изменения преимущественного рестриктивного типа, а также уменьшение диффузионной способности легких [Crofton J., Douglas А., 1974; Sylla А., 1978].
Процесс фиброзировапия продолжается от 6 мес до 2 лет. Учитывая относительно небольшие сроки жизни больных после облучения, в общем, можно считать, что степень фиброза легочной ткани зависит от длительности жизни после проведенной радиационной терапии.
Диагностика радиоционных поражений легких:
Диагностика основывается на данных анамнеза о проводившейся радиационной терапии, площади и локализации облученного поля легких, числе сеансов и их продолжительности. Важным признаком служит односторонность поражения. Следует учитывать также общие симптомы лучевой реакции: слабость, головную боль, потерю аппетита, раздражительность, различные расстройства сердечно-сосудистой системы, лейкопению, тромбо« цитопению и пр., которые нередко предшествуют местным легочным проявлениям лучевого воздействия. Диапюз осложняется в случае присоединения вирусных и бактериальных пневмоний, возникающих вследствие подавления иммунологической защиты организма ионизирующей радиацией.
Лечение радиоционных поражений легких:
Лечение в острую стадию лучевых реакций легочной ткани заключается в приеме кортикостероидов, антибиотиков, антикоа- гулянтов, которые назначаются ввиду угрозы тромбоза легочных капилляров как одного из проявлений повреждающего действия радиации на легкие.
Благоприятное действие кортикостероидов проявляется уже к 3-4-му дню лечения - воспалительный процесс постепенно стихает. Однако если в указанный срок положительный эффект гормональной терапии отсутствует, дальнейшее применение кортикостероидов бесполезно, и, постепенно снижая дозу, их следует отменить. Применение этих препаратов в подострую и хроническую стадии пневмонита неэффективно.
Профилактика радиоционных поражений легких:
Профилактика радиационных повреждений легких состоит прежде всего в индивидуальном определении локализации, объема и конфигурации участков облучения («фигурные поля облучения»). На примере лучевой терапии рака молочной железы показано, что подобный подход к лечению сократил количество осложнений в виде радиационного пневмонита с 70 %, наблюдавшихся ранее, до нескольких процентов. Важное значение имеет также наблюдение за общим состоянием больного - прекращение облучения при появлении стойкой лейкопении и тром- боцитопении, а также при появлении кашля и кровохарканья. Назначение кортикостероидов и антибиотиков в период проведения лучевой терапии не предотвращает развитие патологиче« ского процесса.
К каким докторам следует обращаться если у Вас Радиационные поражения легких:
Вас что-то беспокоит? Вы хотите узнать более детальную информацию о радиоционных поражений легких, ее причинах, симптомах, методах лечения и профилактики, ходе течения болезни и соблюдении диеты после нее? Или же Вам необходим осмотр? Вы можете записаться на прием к доктору .
Хроническая лучевая болезнь
Данная патология формируется под влиянием продолжительного воздействия на организм человека ионизирующей радиации в дозах, которые превосходят предельно допустимые для профессиональной лучевой нагрузки.
Степень выраженности, так же как и время возникновения патологических изменений в пораженных органах и их системах, обусловливаются по большей части характером облучения, которое может быть как общим, так и локальным, суммарной дозой облучения, его типом и интенсивностью, а также физиологическими особенностями структуры и функции того или иного органа. Хроническая лучевая болезнь характеризуется длительностью и волнообразным течением, обусловленным сочетанием прогрессирующих эффектов повреждения с отчетливыми восстановительными и приспособительными реакциями.
Симптомы Хронической лучевой болезни:
В течении хронической лучевой болезни выделяются три периода: формирования заболевания, восстановления и период последствий и исходов хронической лучевой болезни.
По мере увеличения дозы облучения, а также в зависимости от индивидуальных особенностей организма степень развития клинических проявлений может быть легкой (I), средней (II), тяжелой (III) и крайне тяжелой (IV), которые по существу являются фазами в развитии единого патологического процесса и при продолжающемся облучении в достаточно больших дозах последовательно сменяют друг друга.
Ткани и структуры, имеющие большой резерв относительно незрелых клеток, интенсивно обменивающие свой клеточный состав в физиологических условиях (эпителий кожи, кишечника, кроветворная ткань, сперматогенный эпителий), длительно сохраняют возможности морфологического восстановления.
Развивающиеся изменения в системе кровообращения можно квалифицировать как синдром вегетососудистой дисфункции или нейроциркуляторной дистонии. Он выражается общей и регионарной (в сетчатке и сосудах головного мозга) артериальной гипотензией, умеренной брадикардией, быстрым высоким рефлекторным ответом на клино-ортостатические нагрузки. Типичными для развернутой клиники хронической лучевой болезни являются не общие, а регионарные нарушения периферического кровообращения в коже, конечностях, реже - головном мозге, проявляющиеся в виде головных болей, болей в конечностях, повышенной зябкости, общей слабости, иногда преходящих неврологических симптомах. Изменения сердечной деятельности характеризуются нерезко выраженными явлениями миокардиодистрофии, проявляющимися в жалобах на одышку и боли в области сердца, в приглушении тонов и появлении систолического шума на верхушке. На ЭКГ - сглаженность зубца Т и снижение интервала S - Т.
При облучении в диапазоне суммарных доз 0,7-1,5 Гр имеющие место незначительные изменения со стороны пищеварительного тракта длительно не сопровождаются какими-либо субъективными или объективными расстройствами пищеварения. При суммарных дозах облучения, превышающих 1,5-4 Гр, снижается секреторная деятельность желез ротовой полости, возникают очаговые незначительно выраженные атрофические процессы в слизистой рта и желудочно-кишечного тракта, учащаются гистаминрезистентные формы ахлоргидрии.
Функциональные сдвиги со стороны нервной системы в доклинической стадии заболевания, соответствующей суммарному уровню доз порядка 0,15-0,7 Гр, носят рефлекторный характер и часто сопровождаются вовлечением в ответную реакцию эндокринной и сердечно-сосудистой систем.
По мере возрастания суммарных доз, а также интенсивности облучения можно выделить три последовательно развивающихся неврологических синдрома хронической лучевой болезни.
Прежде всего имеется в виду синдром нарушений ней–овисцеральной регуляции, наблюдающийся при нарастании суммарной дозы до 0,71,5 Гр. Он характеризуется асимметричным повышением сухожильных и снижением кожных рефлексов, преходящими вестибулярными расстройствами. Больные жалуются на утомляемость, головные боли, боли в конечностях, головокружения, потливость.
Для астенического синдрома (при суммарной дозе 1,5-4 Гр) характерны общая мышечная гипотония, нарушение физиологического распределения тонуса, легкие нарушения координации, снижение кожных рефлексов, расстройства чувствительности (в виде генерализованных реакций на спонтанную боль и болевое раздражение).
Третий синдром органического поражения нервной системы развивается при высоких дозах облучения (свыше 4 Гр при общем, 10-15 Гр - при местном облучении). В этих случаях наблюдаются симптомы, обычные для той или иной локализации и характера патологического процесса (ишемия, кровоизлияния, образование кисты, некротического участка).
Незначительные изменения в морфологическом составе периферической крови выявляются у лиц, получивших предельно допустимые дозы облучения и превышающие их периодически в 2-3 раза. Они выражаются в виде преходящей лейкопении, тромбоцитопении, ретикулоцитоза. Более существенные изменения в гемограмме обнаруживаются при облучении дозами, систематически превышающими в 2-5 раз предельно допустимые.
Последовательность развития изменений в кроветворной системе при уровне доз 0,001-0,1 Гр в день характеризуется типичной динамикой. В периоде формирования хронической лучевой болезни выявляется нарастающая цитопения за счет уменьшения числа нейтрофилов, лимфоцитов, а позднее – и тромбоцитов. Появление анемии всегда служит неблагоприятным прогностическим признаком и наблюдается лишь при больших суммарных дозах интенсивного облучения.
При облучении в суммарных дозах от 0,15 до 1 Гр не обнаруживается существенных изменений в миелограмме, выявляется лишь незначительное увеличение количества клеток красного ряда и ретикулярных.
При высоких дозах облучения (0,05-0,018 Гр в день и суммарных 1,5-4 Гр) в период формирования хронической лучевой болезни может иметь место угнетение митотической активности клеток костного мозга с развитием признаков его депрессий.
Сведения о состоянии эндокринной сферы при хроническом облучении малочисленны. Развитие стойкой необратимой мужской стерильности имеет место лишь у больных, подвергавшихся лучевой терапии с локальной дозой на яички в 30-40 Гр. У женщин, подвергавшихся общему облучению в суммарных дозах до 4 Гр (разовых - 0,0001-0,001 Гр), не выявлено заметных сдвигов во времени наступления климакса, а также в количестве и течении беременностей, родов.
При профессиональном облучении в щитовидной железе выявляется повышенное включение радиоактивного йода без клинических признаков ее дисфункции. Незначительные сдвиги отмечены также и в деятельности надпочечников.
При тяжести I степени наблюдаются нерезко выраженные нервно-регуляторные нарушения различных органов и систем, особенно сердечно-сосудистой, нестойкая и притом умеренная лейкоцитопения, реже - тромбоцитопения.
При тяжести II степени появляются признаки функциональной недостаточности, особенно пищеварительных желез, сердечно-сосудистой и нервной систем, а также депрессия кроветворения с наличием стойкой лейкоцито- и тромбоцитопении, нарушения обменных процессов.
При тяжести III степени выявляются признаки более глубокого угнетения кроветворения с развитием анемии, обнаруживаются атрофические процессы в слизистой желудочно-кишечного тракта, а также миокардиодистрофия, рассеянный энцефаломиелоз. Ослабление иммунитета влечет за собой инфекционно-септические осложнения. Наблюдаются геморрагический синдром, циркуляторные расстройства.
При хронической лучевой болезни IV степени наблюдаются поносы, выраженное истощение. В связи с тем что такие проявления заболевания в настоящее время практически не встречаются, выделение в классификации IV (крайне тяжелой) степени является условным.
Лечение Хронической лучевой болезни:
Лечение хронической лучевой болезни основывается на прекращении контакта с источниками радиации.
При I и II степенях тяжести заболевания проводится общеукрепляющая и симптоматическая медикаментозная терапия (тонизирующие средства, инсулин с глюкозой, витаминотерапия, транквилизаторы, препараты брома, снотворные), физиотерапевтические процедуры, лечебная гимнастика, рациональная психотерапия.
При развитии инфекционно-септических осложнений используются антибиотики широкого спектра действия.
Особого внимания заслуживает так называемая лучевая болезнь от внутреннего облучения, которая развивается при попадании радиоизотопов внутрь организма и имеет свои отличительные особенности. На основании причинного принципа ее становления различают полониевую, радиевую, плутониевую болезни. Радиоактивные вещества могут проникать в организм путем ингаляции через дыхательные пути, через желудочно-кишечный тракт (с пищей и водой), а также через кожу, особенно поврежденную.
Преимущественно лучевая болезнь от внутреннего облучения представляет собой хроническое заболевание, хотя при попадании в течение небольшого периода времени больших количеств радиоизотопов, особенно способных более равномерно распределяться, может возникнуть и острая лучевая болезнь.
Клинические проявления лучевой болезни от внутреннего облучения складываются из общих симптомов и поражения органов преимущественного поступления радиоактивных веществ, их депонирования и выведения. Так, при ингаляционном заражении доминируют поражения бронхов и легких, при желудочно-кишечном - расстройства пищеварительного тракта. Кроветворная ткань, как правило, вовлекается в процесс, так как большинство радиоактивных веществ или относительно равномерно распределяется в организме, вызывая его общее облучение, или откладывается в костях, лимфоидной, гистиоцитарной тканях. Другие вещества откладываются преимущественно в печени, почках, селезенке.
Для ускорения элиминации естественных и искусственных радиоактивных изотопов из организма были предложены препараты Са2+, гормоны, витамины, средства, стимулирующие обменные процессы, комплексообразующие агенты. Однако в целом проблему удаления из организма радиоизотопов еще нельзя считать окончательно решенной, так как при использовании многих из рекомендованных средств имеют место тяжелые осложнения, наиболее существенные из которых связаны с поражением почек.
К каким докторам следует обращаться если у Вас Хроническая лучевая болезнь:
Вас что-то беспокоит? Вы хотите узнать более детальную информацию о Хронической лучевой болезни, ее причинах, симптомах, методах лечения и профилактики, ходе течения болезни и соблюдении диеты после нее? Или же Вам необходим осмотр? Вы можете записаться на прием к доктору .
Читайте также:
- Надпочечники при ожоговой болезни. Паренхиматозные органы при ожогах
- Очаговая инфильтрация костного мозга и его замещение - лучевая диагностика
- Деформация зубов при рахите. Диагностика деформаций при рахите.
- Поражение височно-нижнечелюстного сустава (ВНЧС) при болезни депонирования пирофосфата кальция дигидрата - лучевая диагностика
- Рентгенограмма, КТ, МРТ при некротизирующем фасциите
